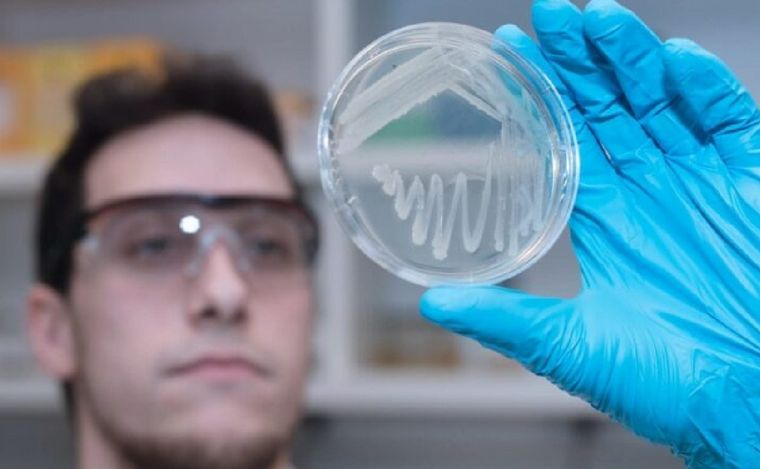

Una empresa elabora plástico biodegradable a partir de residuos industriales
Se trata de un avance que se presenta como una posible solución al problema de la contaminación de los plásticos derivados del petróleo. El proyecto es de la rosarina Inmet.
25/07/2024 | 08:59Redacción Cadena 3
-
Audio. Una empresa elabora plástico biodegradable a partir de residuos industriales
Radioinforme 3
La compañía rosarina Inmet desarrolló una tecnología que permite elaborar plástico biodegradable y compostable a partir de residuos industriales.
Se trata de un avance que se presenta como una posible solución al problema global de la contaminación generada por los plásticos derivados del petróleo.
Leandro Nakamatsu, líder de investigación de biomateriales de Inmet, explicó a Cadena 3 el proceso detrás de esta innovadora tecnología. "En Inmet hace más de 12 años que venimos trabajando en el desarrollo de esta tecnología, que lo que nos permite es convertir, tomar desechos agroindustriales, como por ejemplo glicerina cruda o desechos de la industria del azúcar, usando unas bacterias que nosotros mejoramos. Lo que hacemos es producir un biopolímero, que se llama PHB".
/Inicio Código Embebido/
Mirá también
La buena noticia del día
/Fin Código Embebido/
Este biopolímero tiene un amplio rango potencial de aplicaciones. Puede reemplazar los plásticos tradicionales y también tiene otros usos como laminado para papel con propiedades impermeables y en agricultura sustentable.
Nakamatsu destacó la importancia del avance al ser una tecnología que va a permitir un avance en esta solución que se está buscando.
Otro punto relevante es que no se utilizan solventes orgánicos durante el proceso.
/Inicio Código Embebido/
Mirá también
La buena noticia del día
/Fin Código Embebido/
Informe de Verónica Maslup.